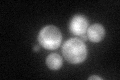
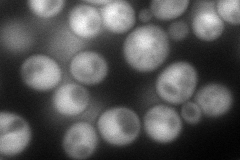
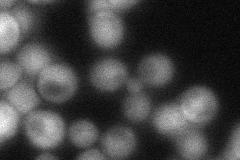
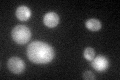

View description
Conserved nuclear regulatory subunit of Glc7p type 1 protein serine-threonine phosphatase (PP1), functions positively with Glc7p to promote dephosphorylation of nuclear substrates required for chromosome transmission during mitosis
Localization:
Intensity:
Fold change:
Significance:
-
C’ GFP library in SD
nucleus:cytosol44.05 -
N' NOP1pr-GFP in SD
cytosol,nucleus167.348 -
N' TEF2pr-mCherry in SD

nucleus257.304 -
N' NATIVEpr-GFP in SD
cytosol48.5299 -
N' TEF2pr-VC and Cyto-VN in SD

#N/A0 -
C’ GFP library in SD+DTT

nucleus.cytosol63.381.43Yes -
C’ GFP library in SD+H2O2

nucleus.cytosol37.590.85No -
C’ GFP library in Starvation Media
nucleus,cytosol75.831.72Yes -
C’ GFP library on the background of Pup2-DaMP

nucleus:cytosol -
C’ GFP library on the background of CCT mutant

nucleus:cytosol51.24291.16318No
